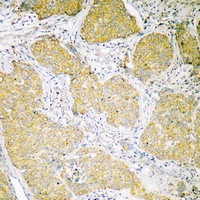
MCU Antibody in Immunohistochemistry (Paraffin) (IHC (P))

Search
Invitrogen
MCU Polyclonal Antibody
{{$productOrderCtrl.translations['antibody.pdp.commerceCard.promotion.promotions']}}
{{$productOrderCtrl.translations['antibody.pdp.commerceCard.promotion.viewpromo']}}
{{$productOrderCtrl.translations['antibody.pdp.commerceCard.promotion.promocode']}}: {{promo.promoCode}} {{promo.promoTitle}} {{promo.promoDescription}}. {{$productOrderCtrl.translations['antibody.pdp.commerceCard.promotion.learnmore']}}
图: 1 / 2
MCU Antibody (PA5-68153) in IHC (P)


Please note: We are reviewing Western blot images included in the antibody testing data in our catalog, including those provided by third parties. Unless expressly labeled or annotated as “raw-unedited”, Western blot images included in the antibody testing data in our catalog may have been edited, optimized or otherwise adjusted for presentation.
产品信息
PA5-68153
种属反应
已发表种属
宿主/亚型
分类
类型
抗原
偶联物
形式
浓度
规格
纯化类型
保存液
内含物
保存条件
运输条件
RRID
产品详细信息
Predicted to react with Mouse samples.
靶标信息
Mitochondrial inner membrane calcium uniporter that mediates calcium uptake into mitochondria. Constitutes the pore-forming and calcium-conducting subunit of the uniporter complex (uniplex). Activity is regulated by MICU1 and MICU2. At low Ca(2+) levels MCU activity is down-regulated by MICU1 and MICU2; at higher Ca(2+) levels MICU1 increases MCU activity. Mitochondrial calcium homeostasis plays key roles in cellular physiology and regulates cell bioenergetics, cytoplasmic calcium signals and activation of cell death pathways. Involved in buffering the amplitude of systolic calcium rises in cardiomyocytes. While dispensable for baseline homeostatic cardiac function, acts as a key regulator of short-term mitochondrial calcium loading underlying a 'fight-or-flight' response during acute stress: acts by mediating a rapid increase of mitochondrial calcium in pacemaker cells. participates in mitochondrial permeability transition during ischemia-reperfusion injury. Regulates glucose-dependent insulin secretion in pancreatic beta-cells by regulating mitochondrial calcium uptake. Mitochondrial calcium uptake in skeletal muscle cells is involved in muscle size in adults. Regulates synaptic vesicle endocytosis kinetics in central nerve terminal. Involved in antigen processing and presentation.
仅用于科研。不用于诊断过程。未经明确授权不得转售。
生物信息学
蛋白别名: Calcium uniporter protein, mitochondrial; coiled-coil domain containing 109A; Coiled-coil domain-containing protein 109A; HsMCU
基因别名: 2010012O16Rik; AV064928; C10orf42; CCDC109A; D130073L02Rik; Gm64; MCU
UniProt ID: (Mouse) Q3UMR5
Entrez Gene ID: (Mouse) 215999